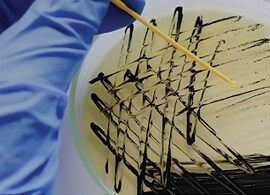
Biochemical identification software downloads Biochemical identification software downloads

Search
Search
From enterococci to staphylococci, biochemical tests provide simple and rapid identification of even the most unusual organisms. Explore our range of biochemical identification test products and choose the right tool for your microorganism identification needs from accurate, simple and convenient biochemical spot tests, stains, and ID panels with supporting software.
Get faster bacterial identification with ready prepared biochemical test panels. Perform multiple tests simultaneously for confidence in results. Visible color reactions and comparison to a database of reactivity patterns from an extensive range of clinical and environmental isolates aid interpretation.
Enhance detection, investigate organism types and meet regulatory requirements with one-step biochemical spot tests, and quality stains and reagents to meet your accuracy needs.
Rapidly obtain a presumptive identification and differentiate microorganisms with our offering of easy-to-use spot tests in disk or strip format, including spot indole, MUG, PYR and many more.
Convenient kits containing tests and reagents.
Perform high-quality identification and classification procedures with our complete collection of microbiology reagents and stains.
Choose the right tool for your biochemical identification needs from our discs and solutions.
Download Thermo Scientific™ RapID™ ERIC™ Software and Thermo Scientific™ Microbact™ Software, and stay up-to-date with our latest updates by visiting our Biochemical Identification Software Downloads portal.
The Thermo Scientific™ RapID™ System's 4 simple steps and ERIC™ software to help you quickly determine your ID results mean you'll never look anywhere else for a manual biochemical ID solution.
Identify infections and antimicrobial susceptibility quickly and accurately to guide optimal patient care with powerful manual and automated technologies, and a comprehensive line of media.